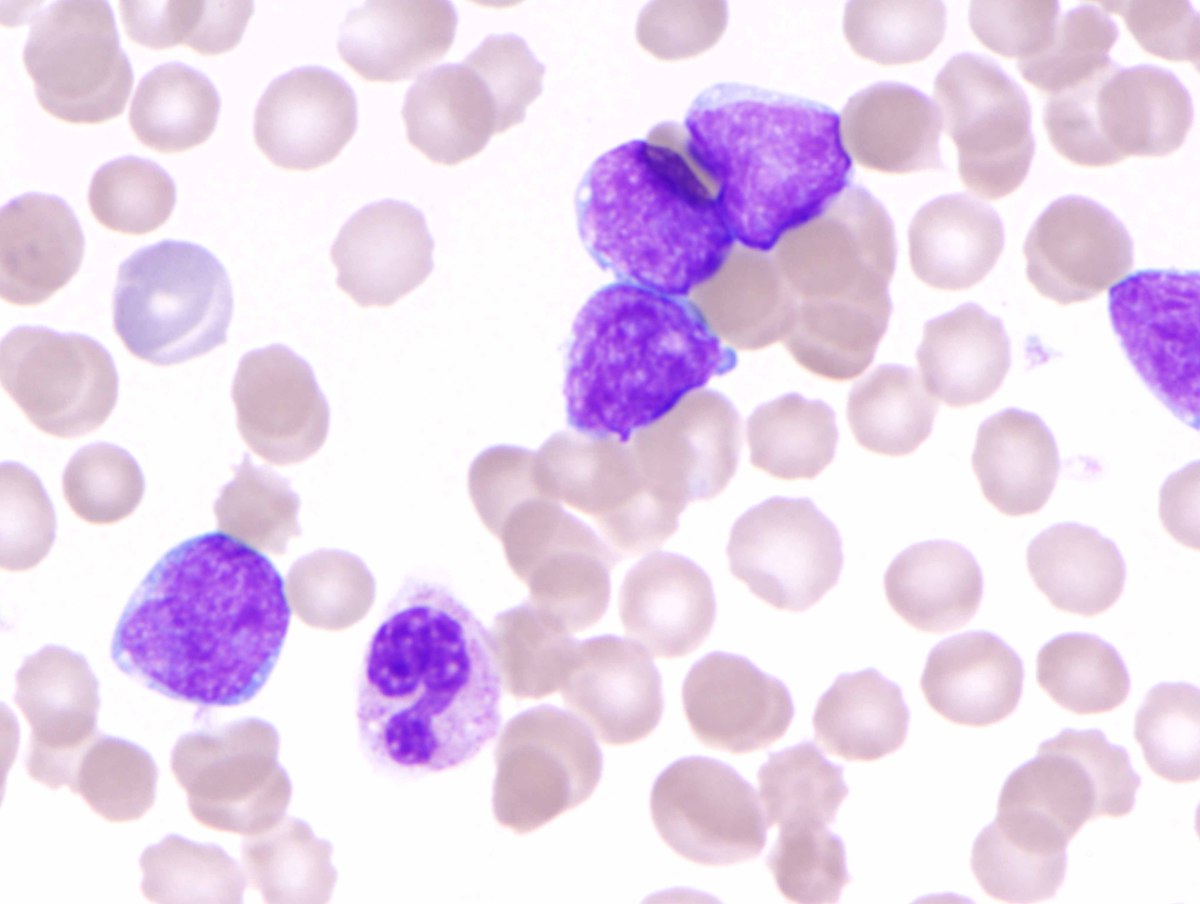
A. Peripheral blood smear (WBC 40.49K/µL) with 76% blasts, intermediate in size with high nuclear:cytoplasmic ratios, slightly irregular nuclear contours, small nucleoli and agranular cytoplasm.  Normocytic anemia with anisocytosis and slight polychromasia is present (H&E, 1000x oil).

Institution: Cleveland Clinic
Additional authors:Karl S. Theil, MD
Session: B Lymphoblastic Leukemia/Lymphoma
HISTORY
The patient is a 56 year-old man with an abnormal white blood cell count (40.49 K/µL) discovered during routine laboratory testing. He had mild fatigue over the past year, but was otherwise asymptomatic. The past medical history included mild hypertension, hyperlipidemia and type 2 diabetes mellitus, but no prior malignant neoplasm. A bone marrow biopsy procedure was performed.
DETAILS
Trephine biopsy – Zinc formalin; Clot section – 10% neutral buffered formalin fixed paraffin-embedded tissue.
The aspirate biopsy shows increased blasts as the predominant cell type (85%), with high nuclear:cytoplasmic ratios, several small nucleoli, and agranular cytoplasm. No Auer rods are seen. Cytochemical stains for myeloperoxidase and non-specific esterase (alpha naphthyl butyrate) show that the blasts are negative for myeloperoxidase and show focal dot-like positivity for non-specific esterase (NSE). Similar results are obtained with repeat of NSE cytochemistry on peripheral blood.The core biopsy is hypercellular (95%) with sheets of large, atypical mononuclear cells that virtually replace the normal bone marrow elements. Mitotic figures are frequent.IMMUNOHISTOCHEMISTRY AND FLOW CYTOMETRY
By flow cytometric analysis of the bone marrow aspirate, the blasts express CD19, CD38, CD45, CD65 and HLA-DR and are negative for the remaining markers tested, including T-cell (negative for CD2, CD3, CD4, CD7, and CD8), plasma cell (negative for CD138 and cytoplasmic kappa and lambda immunoglobulin light chains), B-cell (negative for CD10, CD20, surface and cytoplasmic CD22, CD79a, surface and cytoplasmic IgM, and surface kappa and lambda immunoglobulin light chains) and myeloid and monocytic markers (negative for CD11b, CD13, CD14, CD16, CD33, CD34, CD64, CD65, and myeloperoxidase). In addition, CD56, TdT, and CD117 are not expressed by the blasts using flow cytometry.
Immunohistochemical stains for cytoplasmic CD3 (monoclonal) and lysozyme show scattered reactive T-cells and monocytes respectively, but blasts appear negative. In addition, there is no evidence of megakaryocytic (CD61-), monocytic (CD68- and CD163-) or plasmacytoid dendritic cell (CD123-) differentiation based on immunostains of the core biopsy. Immunohistochemical stains for CD79a (a different clone than by flow) and PAX5 are positive.CYTOGENETIC FINDINGS
46,XY,t(4;11)(q21;q23)[12]/46,XY[8]
Interphase fluorescence in situ hybridization (FISH) is positive for a translocation involving the MLL gene (11q23). FISH is negative for the t(9;22) BCR/ABL1 translocation.INTERESTING FEATURES
This case is an example of a B-lymphoblastic leukemia with t(4;11)(q21;q23) which bears an early, pro-B immunophenotype (CD10-, CD19+, HLADR+) with a co-expression of the myeloid-associated antigen CD65. The blast morphology is nonspecific, and the differential diagnosis based on morphologic features includes lymphoblastic leukemia, minimally differentiated acute myeloid leukemia and undifferentiated leukemia. A significant diagnostic issue in this case is that lineage assignment was inconclusive on the basis of morphology, cytochemistry and flow cytometry. The expression of CD19 alone is insufficient for assignment to the B-lineage according to the WHO or by the EGIL scoring system. The FISH results were not immediately available, but MLL translocations are also not lineage specific. Immunohistochemistry (IHC) allowed definitive lineage assignment, but not without an associated delay. The “undifferentiated” immunophenotype that was initially observed in this case may be a reflection of the hypothesis that the transformation event in these leukemias involves a stem cell with the capacity for both lymphoid and myeloid differentiation.
Blasts with 11q23 rearrangements may have myelomonocytic characteristics or monocytic differentiation, but this case lacked monocytic marker expression by flow cytometry and IHC and the dot-like appearance of the non-specific esterase cytochemical stain does not support monocytic derivation. The patient lacked hyperleukocytosis, splenomegaly and CNS involvement, which are frequently associated with this type of leukemia. The t(4;11)(q21;q23) chromosomal abnormality is more often detected in infants by standard cytogenetic karyotyping than in adults. An unusual feature of this case is the lack of prior treatment with topoisomerase II inhibitors. The patient underwent induction chemotherapy with cyclophosphamide, daunorubicin, vincristine, prednisone and L-asparaginase. His 1 month post-diagnosis bone marrow biopsy was negative for leukemia but he will receive consolidation chemotherapy and hopefully progress to allogeneic hematopoietic stem cell transplantation given the unfavorable risk associated with MLL-rearranged leukemia.PROPOSED DIAGNOSIS
B-lymphoblastic leukemia with t(4;11)(q21;q23); MLL-rearranged
CONSENSUS DIAGNOSIS
B-acute lymphoblastic leukemia with t(4;11)(q21;q23); MLL-rearranged
| A. Peripheral blood smear (WBC 40.49K/µL) with 76% blasts, intermediate in size with high nuclear:cytoplasmic ratios, slightly irregular nuclear contours, small nucleoli and agranular cytoplasm. Normocytic anemia with anisocytosis and slight polychromasia is present (H&E, 1000x oil). | |
| B. Bone marrow aspirate showing increased blasts with similar morphology as those present in the peripheral blood (H&E, 1000x oil). |  |
| C. Bone marrow core biopsy which is hypercellular and subtotally replaced by sheets of blasts (H&E, 40x). |  |
| D. Bone marrow core biopsy shows atypical mononuclear cells consistent with blasts with dispersed chromatin, small nucleoli and frequent mitotic figures (H&E, 500x oil). |  |
| E. Bone marrow core biopsy showing rare monocytic cells (dark cytoplasmic staining) and patchy, artifactual nuclear blush on the blast cells (muramidase, 500x). |  |
| F. NSE cytochemistry showing nonspecific block-like staining in the leukemic blasts (NSE, 1000x oil) with diffuse cytoplasmic staining in a monocyte as a positive internal control (inset). |  |
| G. Bone marrow core biopsy positive for B-lineage markers (Left – CD79a, Right – PAX5; 1000x oil) |  |
| H. Partial karyogram demonstrating t(4;11)(q21;q23). |  |
| I. Selected flow cytometric dot plots demonstrating limited expression of antibodies by the blasts (blasts are purple, CD45 dim). |  |